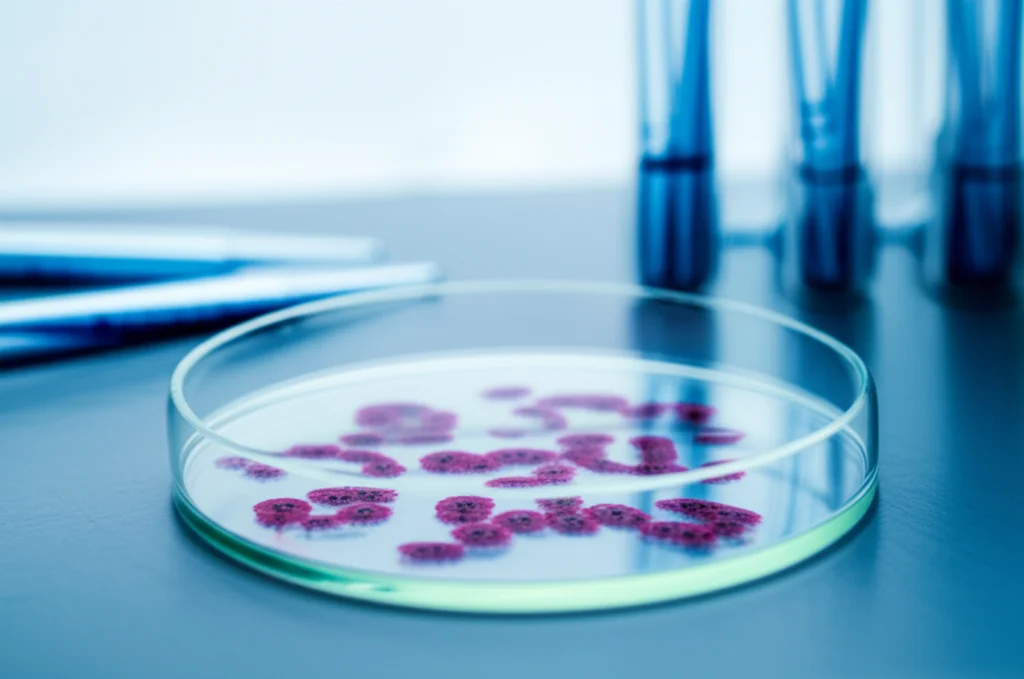
Immagine di laboratorio che mostra vetrini da microscopio con campioni di sangue di pesce, 60mm Macro lens, alta definizione, illuminazione da laboratorio controllata. In primo piano un vetrino con cellule del sangue visibili, sullo sfondo sfocato altri strumenti di analisi come pipette e provette, a simboleggiare l'analisi ematologica.

Alghe Brune: Il Superfood Segreto per Pesci Gatto Africani Più Forti e Sani?
Ciao a tutti, appassionati di scienza e curiosi del mondo acquatico! Oggi voglio parlarvi di una ricerca che mi ha davvero stuzzicato la fantasia, una di quelle che apre prospettive interessanti per un settore cruciale come l’acquacoltura. Sappiamo bene quanto sia importante allevare pesce in modo sostenibile e, soprattutto, garantendo il benessere degli animali. E se vi dicessi che un’umile alga bruna potrebbe darci una grossa mano?
L’Acquacoltura e le sue Sfide
Prima di tuffarci nei dettagli, facciamo un piccolo passo indietro. L’acquacoltura è in piena espansione, un vero pilastro per soddisfare la crescente domanda di proteine animali. Pensate che si stima una produzione di pesce di circa 109 milioni di tonnellate entro il 2030! Tra i protagonisti di questa crescita c’è il nostro amico Clarias gariepinus, il pesce gatto africano. È un tipo tosto: cresce in fretta, è molto richiesto e ci fornisce un sacco di acidi grassi e amminoacidi essenziali. Lo si alleva un po’ ovunque, in stagni, gabbie, sistemi a ricircolo, grazie alla sua grande adattabilità.
Però, come in tutte le cose, c’è un “ma”. L’intensificazione degli allevamenti, con alte densità di pesci, può causare stress. E un pesce stressato, ahimè, è un pesce più vulnerabile alle malattie. Le epidemie, infatti, sono un bel grattacapo per gli allevatori di pesce gatto africano, causando perdite economiche non da poco. Per anni si è fatto ricorso ad antibiotici e farmaci, ma oggi siamo tutti più consapevoli dei rischi: ceppi batterici resistenti, immunodepressione nei pesci, residui chimici nell’ambiente… Insomma, c’è un gran bisogno di alternative più “verdi” ed efficaci.
La Natura ci Viene in Soccorso: Gli Estratti Vegetali
Ed è qui che entrano in gioco gli estratti vegetali! Sono sulla cresta dell’onda come ingredienti funzionali nei mangimi per pesci. L’idea è semplice ma geniale: usare il potere della natura per migliorare la crescita, le difese immunitarie e la resistenza dei pesci alle malattie. Pensate che sono già stati studiati con successo estratti di basilico africano, cipolla, e altre piante terrestri proprio sul Clarias gariepinus.
Ma il mondo acquatico stesso è un tesoro di biodiversità ancora poco esplorato. E tra questi tesori ci sono le macroalghe marine, le cosiddette “seaweeds”. Sono ricchissime di composti bioattivi – polifenoli, carotenoidi, polisaccaridi, e chi più ne ha più ne metta – che potrebbero fare faville per il benessere di pesci e crostacei. In particolare, le alghe brune come Padina, Sargassum e Laminaria hanno già mostrato proprietà antimicrobiche e immunostimolanti promettenti.
Focus sull’Alga Bruna Dictyota ciliolata
E qui arriviamo al cuore della nostra storia. C’è un’alga bruna tropicale, la Dictyota ciliolata, i cui effetti sul nostro pesce gatto africano non erano ancora stati indagati a fondo. Così, un gruppo di ricercatori (e mi ci metto in mezzo idealmente, perché questi studi mi appassionano da matti!) ha deciso di vederci chiaro. Hanno raccolto quest’alga nella baia di Lagos, in Nigeria, l’hanno pulita per bene, essiccata, polverizzata e poi, con un metodo chiamato macerazione, ne hanno ottenuto un estratto etanolico, che chiameremo DCE (Dictyota ciliolata extract).
Questo estratto è stato poi analizzato per scoprire quali “ingredienti segreti” contenesse. Ebbene, è risultato positivo per un bel po’ di composti interessanti: alcaloidi, tannini (molto abbondanti!), flobatannini, glicosidi, saponine (anche queste in quantità!), fenoli, steroidi, terpenoidi (presenti in buona misura!) e flavonoidi. Un vero cocktail di molecole potenzialmente benefiche!

L’Esperimento: Pesci Gatto a Dieta Speciale
A questo punto, i ricercatori hanno preparato quattro diete sperimentali, tutte con lo stesso apporto proteico e calorico. Una era la dieta di controllo (senza DCE), le altre tre contenevano l’estratto di Dictyota ciliolata a diverse concentrazioni: 0.25 g/kg, 0.5 g/kg e 1.0 g/kg di mangime. Hanno preso 120 giovani pesci gatto (circa 14.5 grammi l’uno, dei pesciolini!), li hanno divisi in gruppi e li hanno nutriti tre volte al giorno per 28 giorni, tenendo sotto controllo la qualità dell’acqua (temperatura, pH, ossigeno disciolto – tutto nella norma, per fortuna).
Cosa volevano scoprire? Beh, un po’ di tutto: come crescevano i pesci, quanto bene utilizzavano il mangime, come stavano i loro parametri ematici e biochimici, l’attività antiossidante nel fegato e le risposte immunitarie. Un check-up completo, insomma!
I Risultati: Cosa ci Dice la Scienza?
E ora, tenetevi forte, arrivano i risultati! È la parte più succosa, quella che ci dice se la nostra alga ha mantenuto le promesse.
Performance di Crescita e Utilizzo del Mangime
Partiamo dalla crescita. Sorpresa (o forse no?): non ci sono state differenze significative nel peso finale, nell’incremento di peso o nel tasso di crescita specifico tra i vari gruppi. Questo significa che, almeno in questo studio, l’estratto di Dictyota ciliolata non ha dato una spinta “turbo” alla crescita dei pesci gatto. Risultati simili sono stati osservati anche in altri studi con alghe brune su gamberi e branzini. Sembra che l’effetto sulla crescita dipenda molto dalla specie di pesce, dalla dose di alga e dai suoi composti specifici.
Ma attenzione! Anche se non sono diventati più grossi più in fretta, i pesci nutriti con le diete contenenti DCE hanno mostrato un miglior utilizzo del mangime. Avevano un rapporto di conversione alimentare (FCR) più basso – il che significa che hanno avuto bisogno di meno mangime per crescere della stessa quantità – e un rapporto di efficienza proteica (PER) più alto. In pratica, hanno “sprecato” meno cibo! Il gruppo DCE-0.25 (quello con la dose più bassa di estratto) è stato il migliore sotto questo aspetto. Questo potrebbe essere dovuto all’alta concentrazione di saponine nell’estratto, note per promuovere l’attività degli enzimi digestivi nei pesci.
Un Check-up del Sangue: Indizi sulla Salute
Il profilo ematico è come una fotografia dello stato di salute di un animale. E qui le notizie sono buone! I pesci alimentati con le diete DCE-0.25 e DCE-0.5 avevano livelli significativamente più alti di emoglobina, globuli bianchi (WBC) e globuli rossi (RBC) rispetto al gruppo di controllo. Più globuli rossi ed emoglobina significano una migliore capacità di trasportare ossigeno, mentre più globuli bianchi indicano un sistema immunitario più reattivo e competente. Anche il numero di linfociti era più alto nel gruppo DCE-0.25. Questi risultati suggeriscono che l’estratto algale potrebbe stimolare la produzione di cellule del sangue, rafforzando così i pesci. Probabilmente, i composti fenolici come flavonoidi, alcaloidi, saponine e terpenoidi presenti nell’estratto giocano un ruolo chiave in questa bioattività.
Per quanto riguarda proteine sieriche, albumina, globulina e lipidi, non ci sono state grosse variazioni, il che indica che l’estratto non ha alterato le normali funzioni fisiologiche dei pesci. Tuttavia, un dato interessante è la riduzione significativa dei trigliceridi nel siero dei pesci che hanno mangiato DCE. Questo suggerisce proprietà ipolipemizzanti, un effetto positivo visto che alti livelli di trigliceridi e colesterolo possono essere legati a condizioni di stress.
Fegato Sotto Controllo e Attività Antiossidante Potenziata
Gli enzimi epatici come l’ALT (alanina aminotransferasi) sono usati come indicatori di possibili danni al fegato. In questo studio, i livelli di ALT non sono cambiati, il che ci dice che l’estratto di Dictyota ciliolata non è tossico per il fegato dei pesci. Invece, un altro enzima, l’ALP (fosfatasi alcalina), è aumentato nei gruppi DCE-0.5 e DCE-1.0. Questo non è necessariamente un male; anzi, potrebbe indicare una migliore scomposizione dell’energia necessaria per il benessere del pesce.
Ma la vera star qui è l’attività antiossidante! Come noi, anche i pesci hanno un sistema di difesa antiossidante per proteggersi dai radicali liberi. L’estratto DCE ha potenziato queste difese. I pesci trattati hanno mostrato un aumento dell’attività di enzimi come la superossido dismutasi (SOD), il glutatione ridotto (GSH), la glutatione-S-transferasi (GST) e la catalasi (CAT). Di conseguenza, si è osservata una riduzione della perossidazione lipidica (misurata come livelli di MDA) nel tessuto epatico. In pratica, meno danni da stress ossidativo! Le alghe brune sono ricche di florotannini, un tipo speciale di tannini con potenti capacità antiossidanti, e probabilmente sono loro i principali responsabili di questo effetto scudo.
Un Sistema Immunitario Più Reattivo
E veniamo al sistema immunitario. Le citochine sono molecole segnale che regolano le risposte immunitarie, incluse quelle infiammatorie. Nello studio, la somministrazione di DCE ha portato a un aumento significativo dei livelli di citochine pro-infiammatorie come il TNF-α (fattore di necrosi tumorale alfa), l’IL-1β (interleuchina-1 beta) e l’IL-6 (interleuchina-6) nel tessuto epatico dei pesci gatto. Il TNF-α è importante per lo sviluppo dei linfociti, l’IL-1β attiva i macrofagi (le cellule “spazzine” del sistema immunitario) e l’IL-6 stimola l’attività proliferativa dei fagociti. Questo “sprint” del sistema immunitario potrebbe essere dovuto alla presenza di alcaloidi e glicosidi nell’estratto, noti per le loro proprietà immunostimolanti.
Conclusioni: Un Alleato Prezioso per il Benessere dei Pesci
Quindi, cosa ci portiamo a casa da questa affascinante ricerca? Anche se l’estratto di Dictyota ciliolata non ha fatto crescere i pesci gatto africani più velocemente, ha dimostrato di essere un ingrediente funzionale di grande valore. I pesci che lo hanno assunto hanno utilizzato meglio il mangime, hanno mostrato un miglioramento dei parametri ematici, un potenziamento delle difese antiossidanti e una stimolazione delle risposte immunitarie. Tutti fattori che contribuiscono a migliorare il benessere generale dei pesci in acquacoltura.
Certo, la ricerca non si ferma qui. I prossimi passi potrebbero concentrarsi sull’identificazione dei composti bioattivi specifici all’interno dell’estratto di D. ciliolata e su come questi possano ottimizzare l’espressione dei geni legati alla tolleranza allo stress e alla resistenza alle malattie nei pesci. Ma una cosa è chiara: il mare nasconde ancora tanti segreti e tante soluzioni per un futuro più sostenibile, anche nel piatto!
Fonte: Springer
